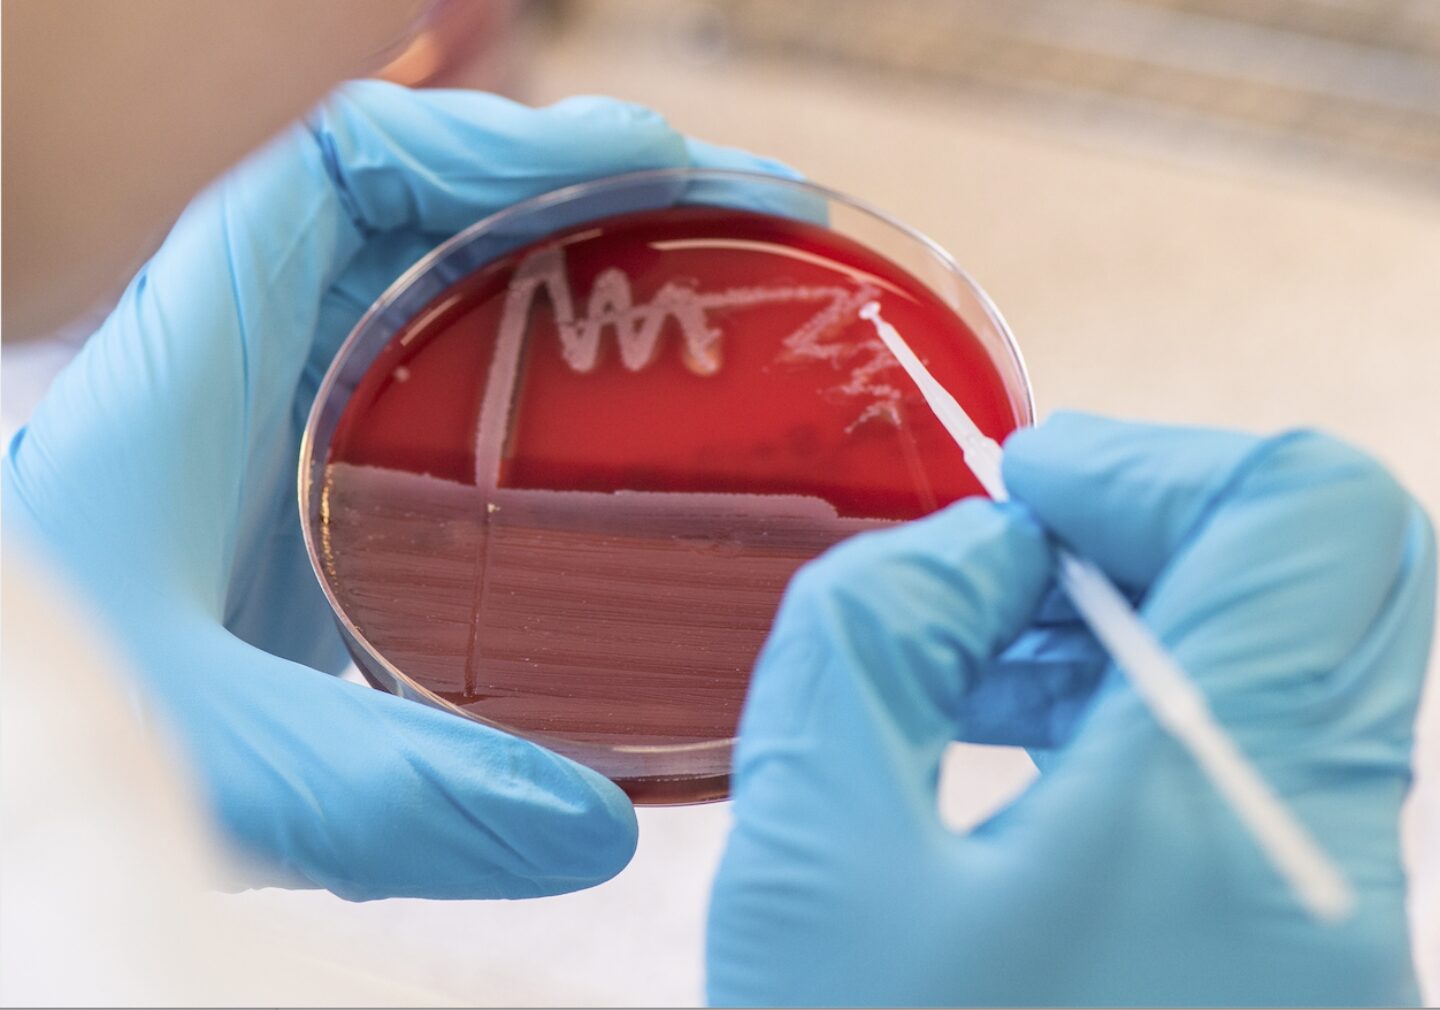

JUST4VETS +
Vulvitis, Vaginitis – wie angemessen reagieren?
Oft beginnt es schon beim wenige Wochen alten Welpen: In den Achselhöhlen, auf dem noch unbehaarten Bauch und auf den Innenschenkeln entwickelt sich ein Erythem mit Pusteln und eitrigen Pickeln, das nicht selten ausgeprägten Juckreiz verursacht und sich unter dem Kratzen des Tieres zusehends verschlimmert. Spätestens, wenn zu diesen Hautveränderungen graugrüner bis grüngelber Ausfluss aus der Vulva hinzukommt, werden die Welpen in der Praxis vorgestellt.
Welpenpyodermie (Impetigo) und Junghundvaginitis
Bei der tierärztlichen Untersuchung wird dann oft eine Entzündung der Vulva-Falte, eine Vul